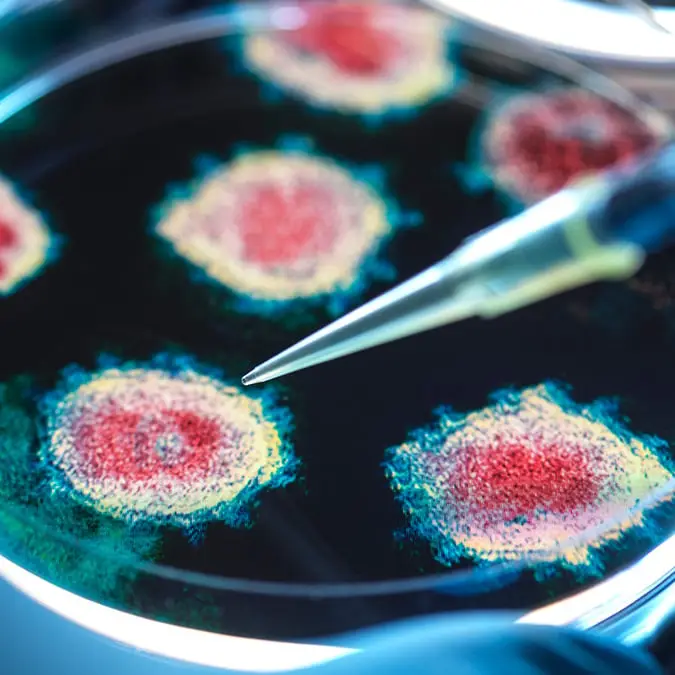
Scientists discover new bat coronavirus in China that sparks pandemic fears

Scientists have shockingly uncovered a new bat coronavirus in China.
The discovery has sparked fears that a new pandemic could be on the horizon.
Just five years after the Covid outbreak spread across the world, scientists have found a new strain of the virus.

Advert
The new virus is named HKU5-CoV-2 and is similar to the virus that causes Covid-19.
This is according to reports made by the South China Morning Post.
The research team that found the new strain was led by Zheng-Li Shi at Guangzhou Laboratory in Guangdong, China.
In a study, researchers wrote: “This study reveals a distinct lineage of HKU5-CoVs in bats that efficiently use human ACE2 and underscores their potential zoonotic risk.”
Speaking to Fox News Digital, Dr Marc Siegel, who is a clinical professor of medicine at NYU Langone Health and a Fox News senior medical analyst, said: “In this case, Shi-Zhengli discovered that a pipistrellus species of bats is carrying a HKU5-COV2 coronavirus that is a cousin of the MERS virus, which caused a limited outbreak in humans in 2012.
"This particular strain has an ability to bind to the same receptor in the lungs, nose and respiratory passages that allowed SARS-CoV-2 (COVID-19) to infect humans — so there is a chance of what is known as zoonotic spillover, where this virus could also infect humans and go human to human.”

However, while there have been fears about what this could mean for the future, the discovery doesn’t necessarily indicate that a pandemic is approaching.
The expert went on to state that he believes the risk of a new pandemic is ‘very low’ because the virus is ‘much less powerful’ than Covid-19.
Siegel continued: “Even as we continue to investigate potential human pathogens, and even as we prepare for possible pandemics, it is very important that we not give in to fear.
“The COVID pandemic is the worst in a century, but it doesn’t mean another is about to happen from bird flu or this or anything else.”
The doctor also said that he is in favor of a group of scientists being formed to help with global health protection.
He added: “That certainly did not happen with the COVID pandemic, and the cloak of secrecy remains," he said. "But studies like this, published in a prominent journal, are a step in the right direction.
“What we know far less about is exactly what research on bat coronaviruses is being conducted in that lab.”